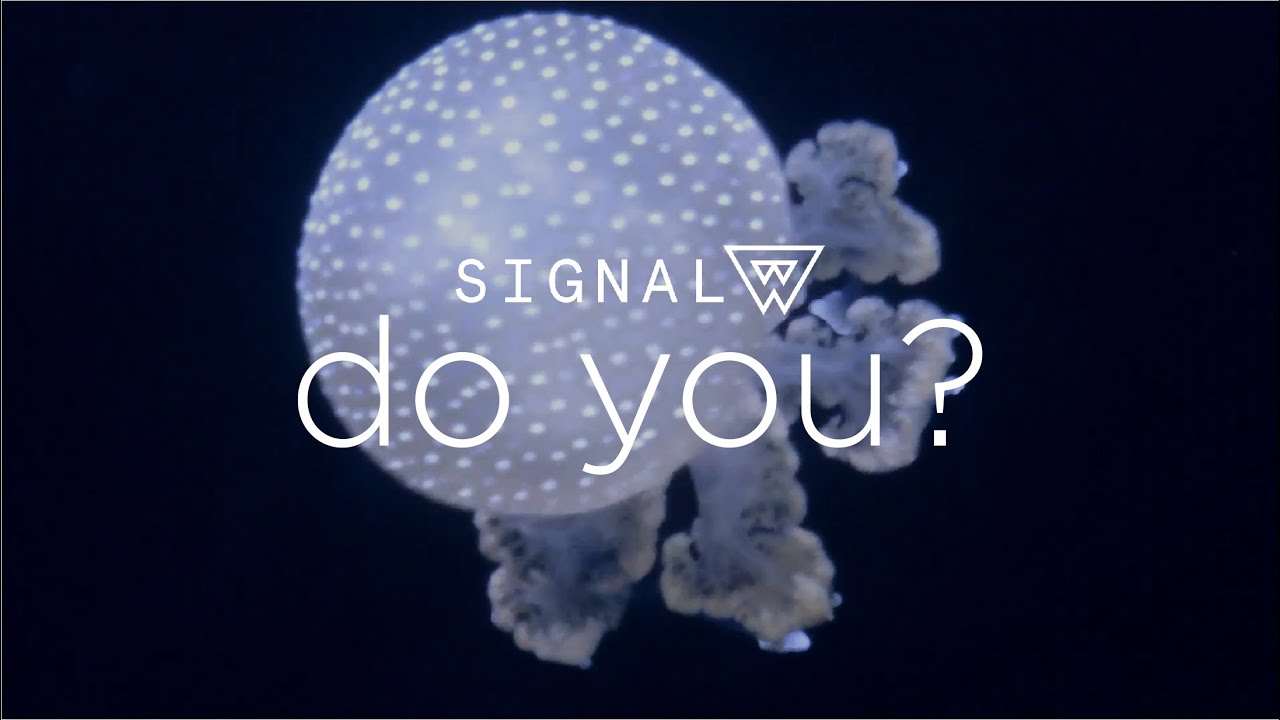

Music Video
Music Video
Credits
COMPOSITION & LYRICS

Nihar Apte
Songwriter

Anukool Raman
Songwriter

Devasheesh Sharma
Songwriter

Joe Panicker
Songwriter
Lyrics
When I talk to and you smile
Leaving things turned upside
I haven't seen you in a while
Let me take you out with me tonight
When the noon runs out of light
Let me ask a question if I might
Will you come with me tonight?
Cause I want you by my side
So many things that I can't say
Not many words can put it that way
You'll have to read between the lines
Let me take you out with me tonight
Do you have something to say?
Let me help you get it out of the way
You can break me if you like
But let me take you out with me tonight
Sail out tonight
Written by: Anukool Raman, Devasheesh Sharma, Joe Panicker, Nihar Apte